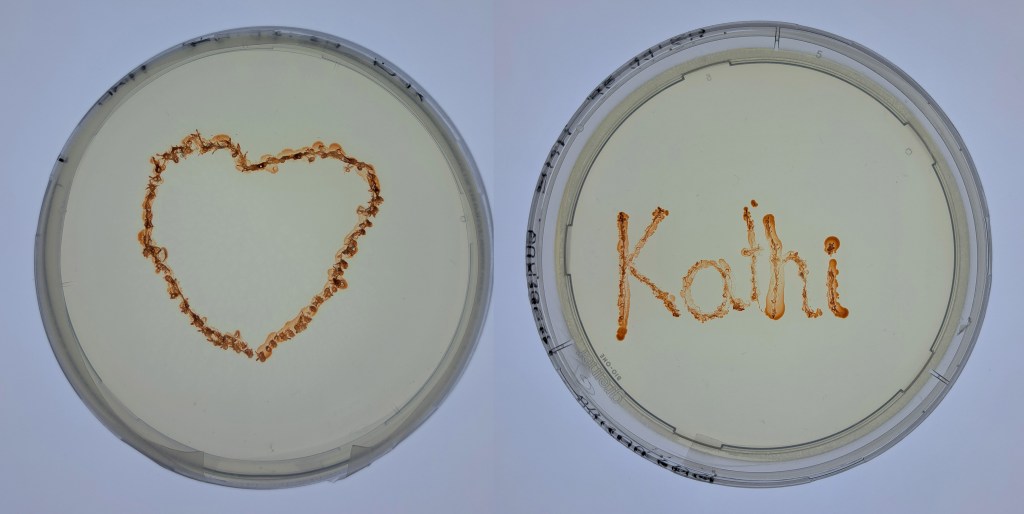
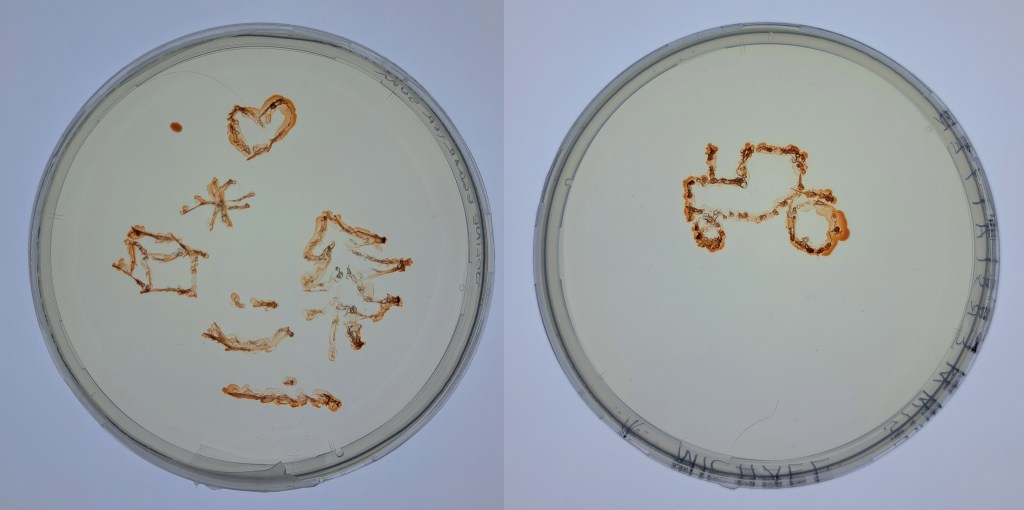
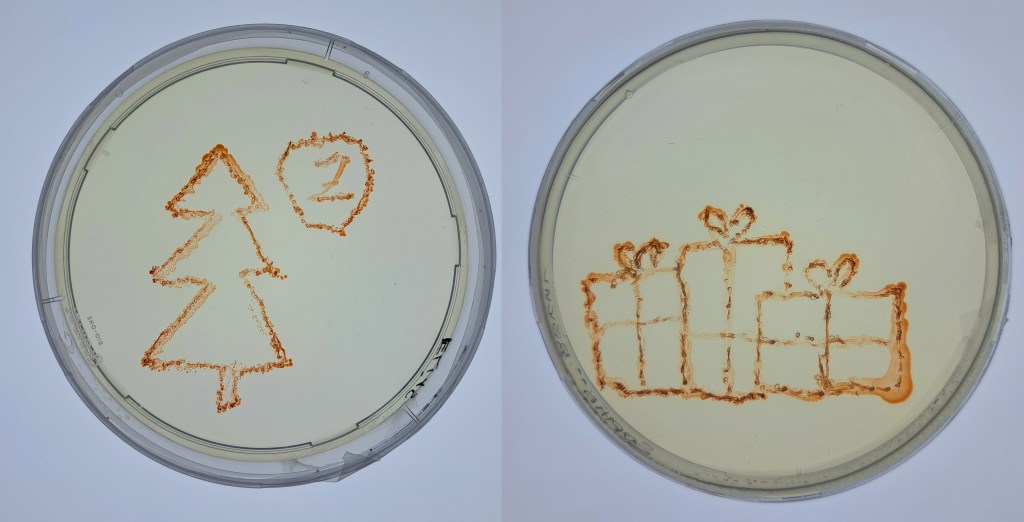
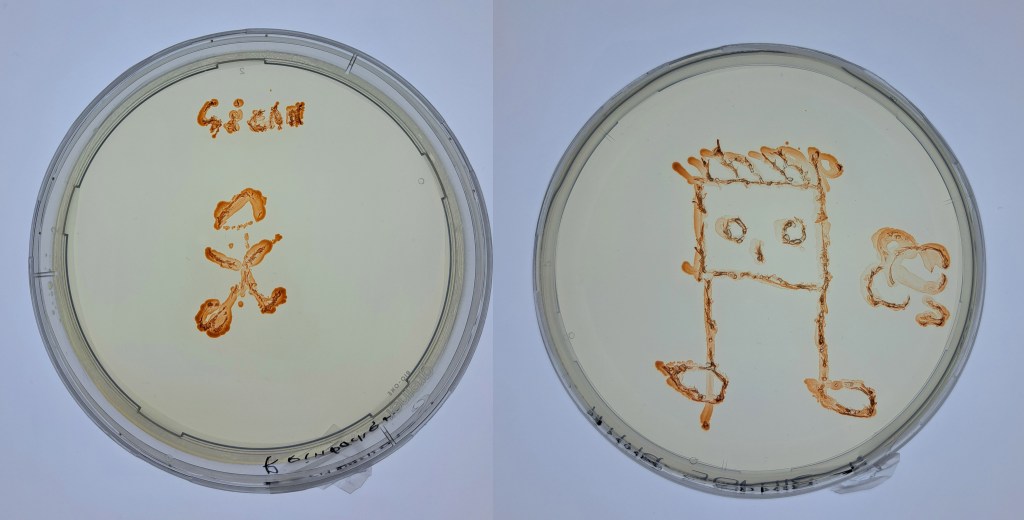
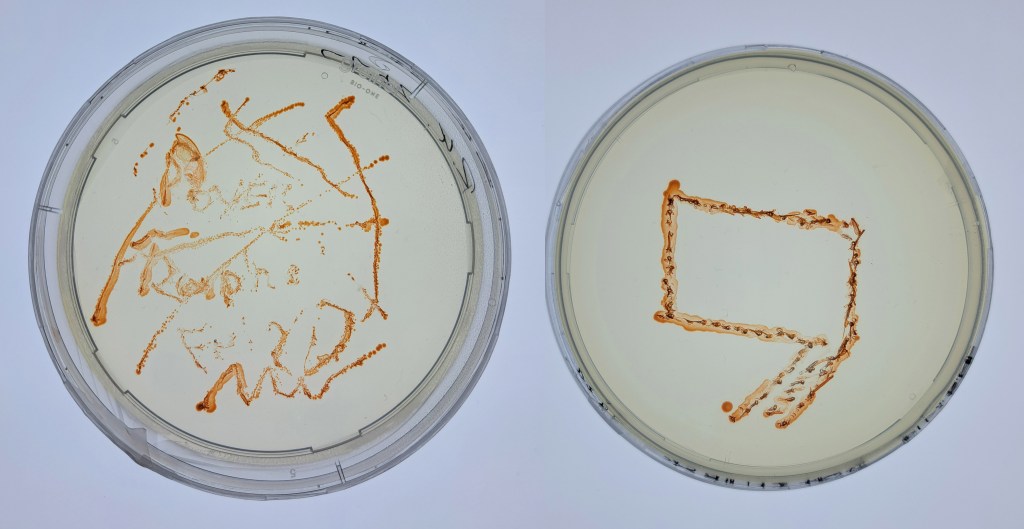
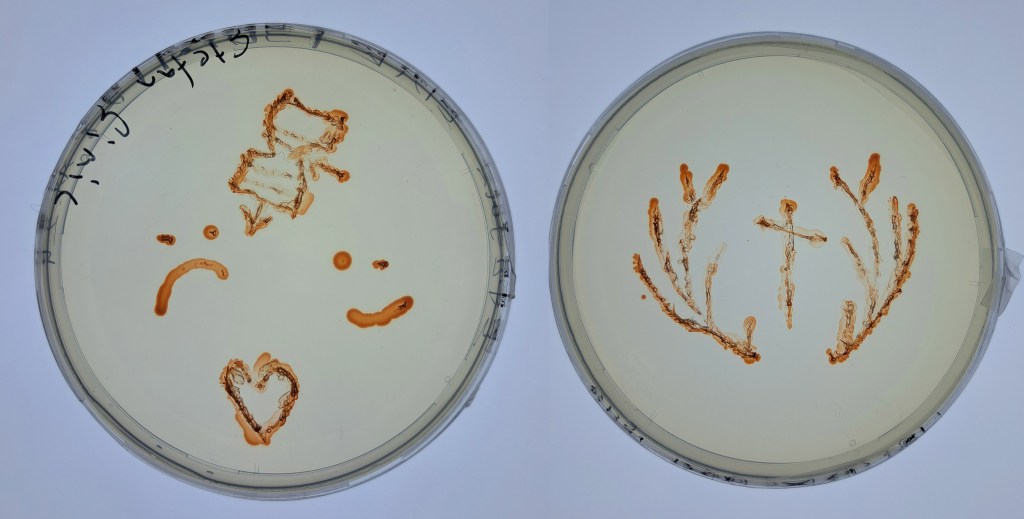
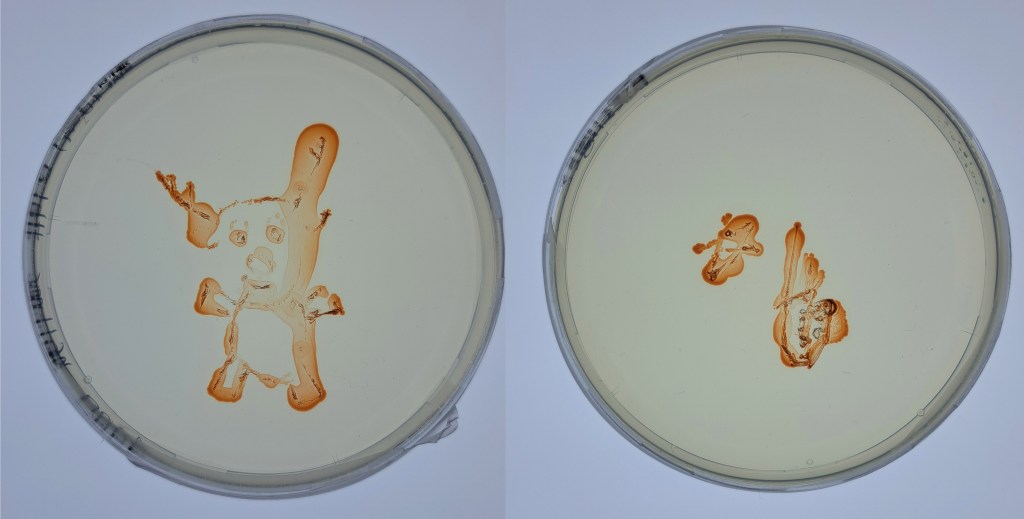
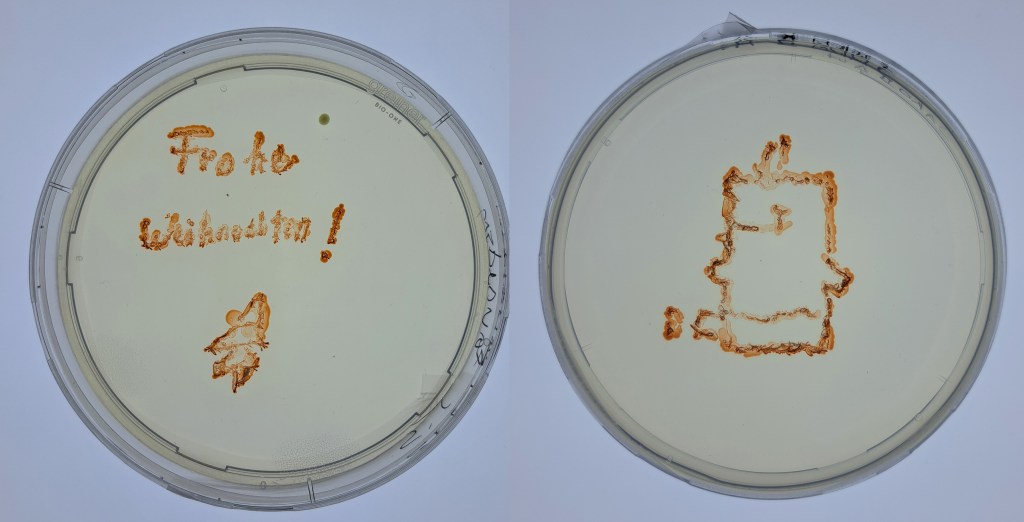
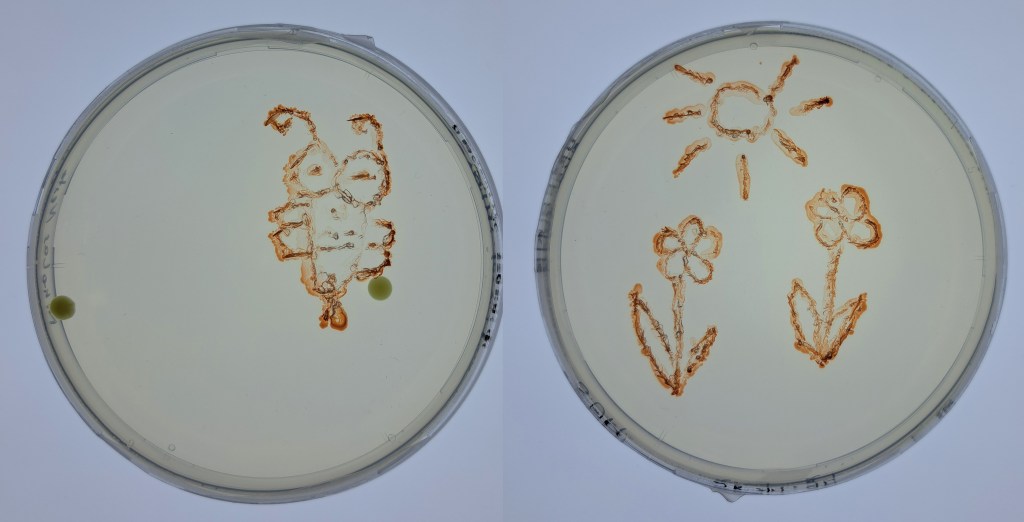
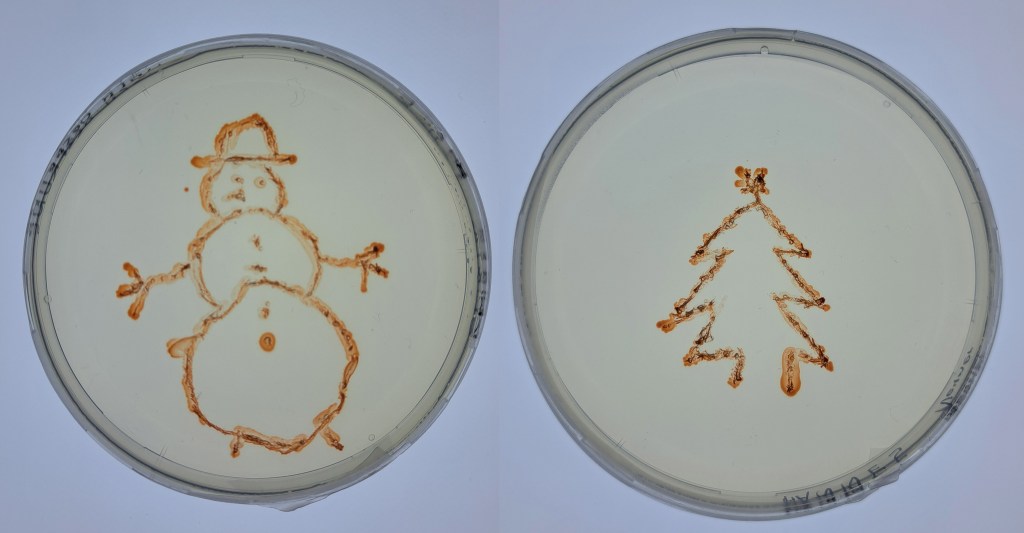
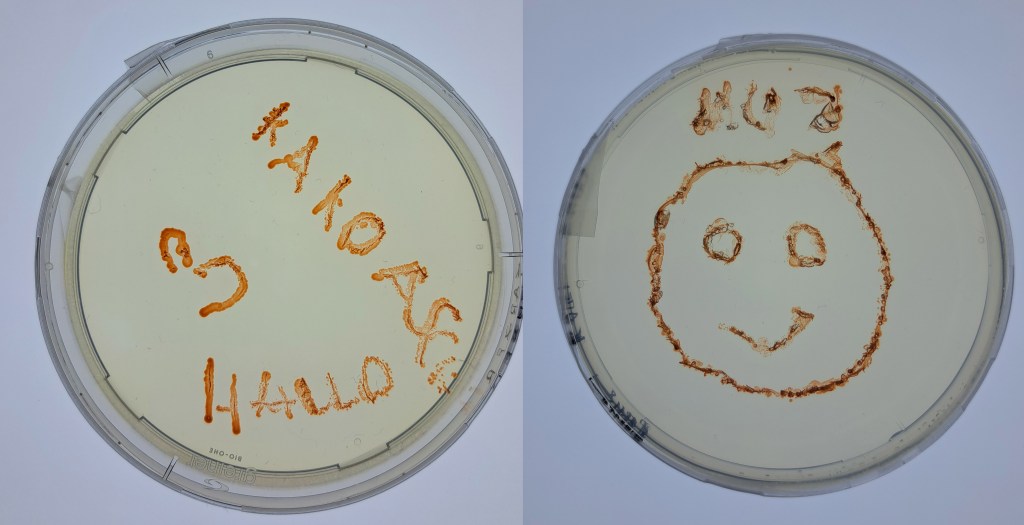
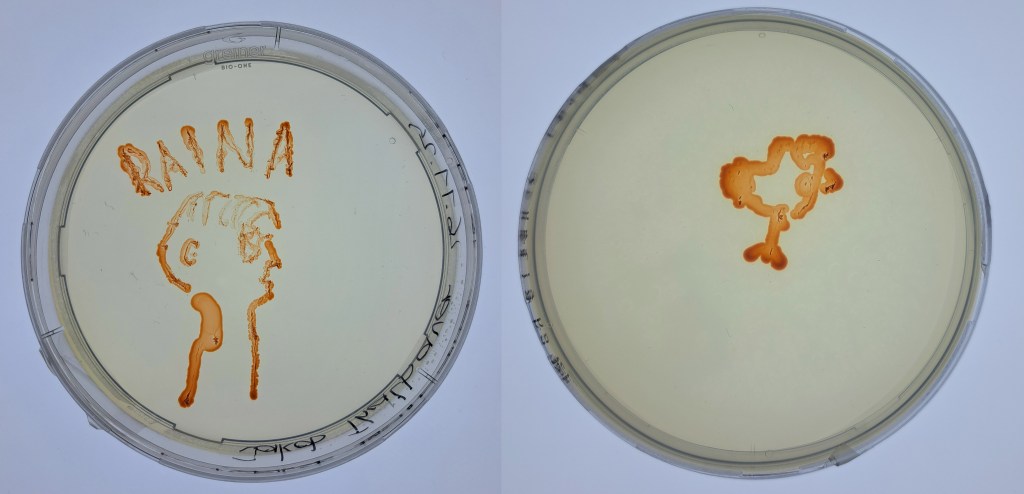
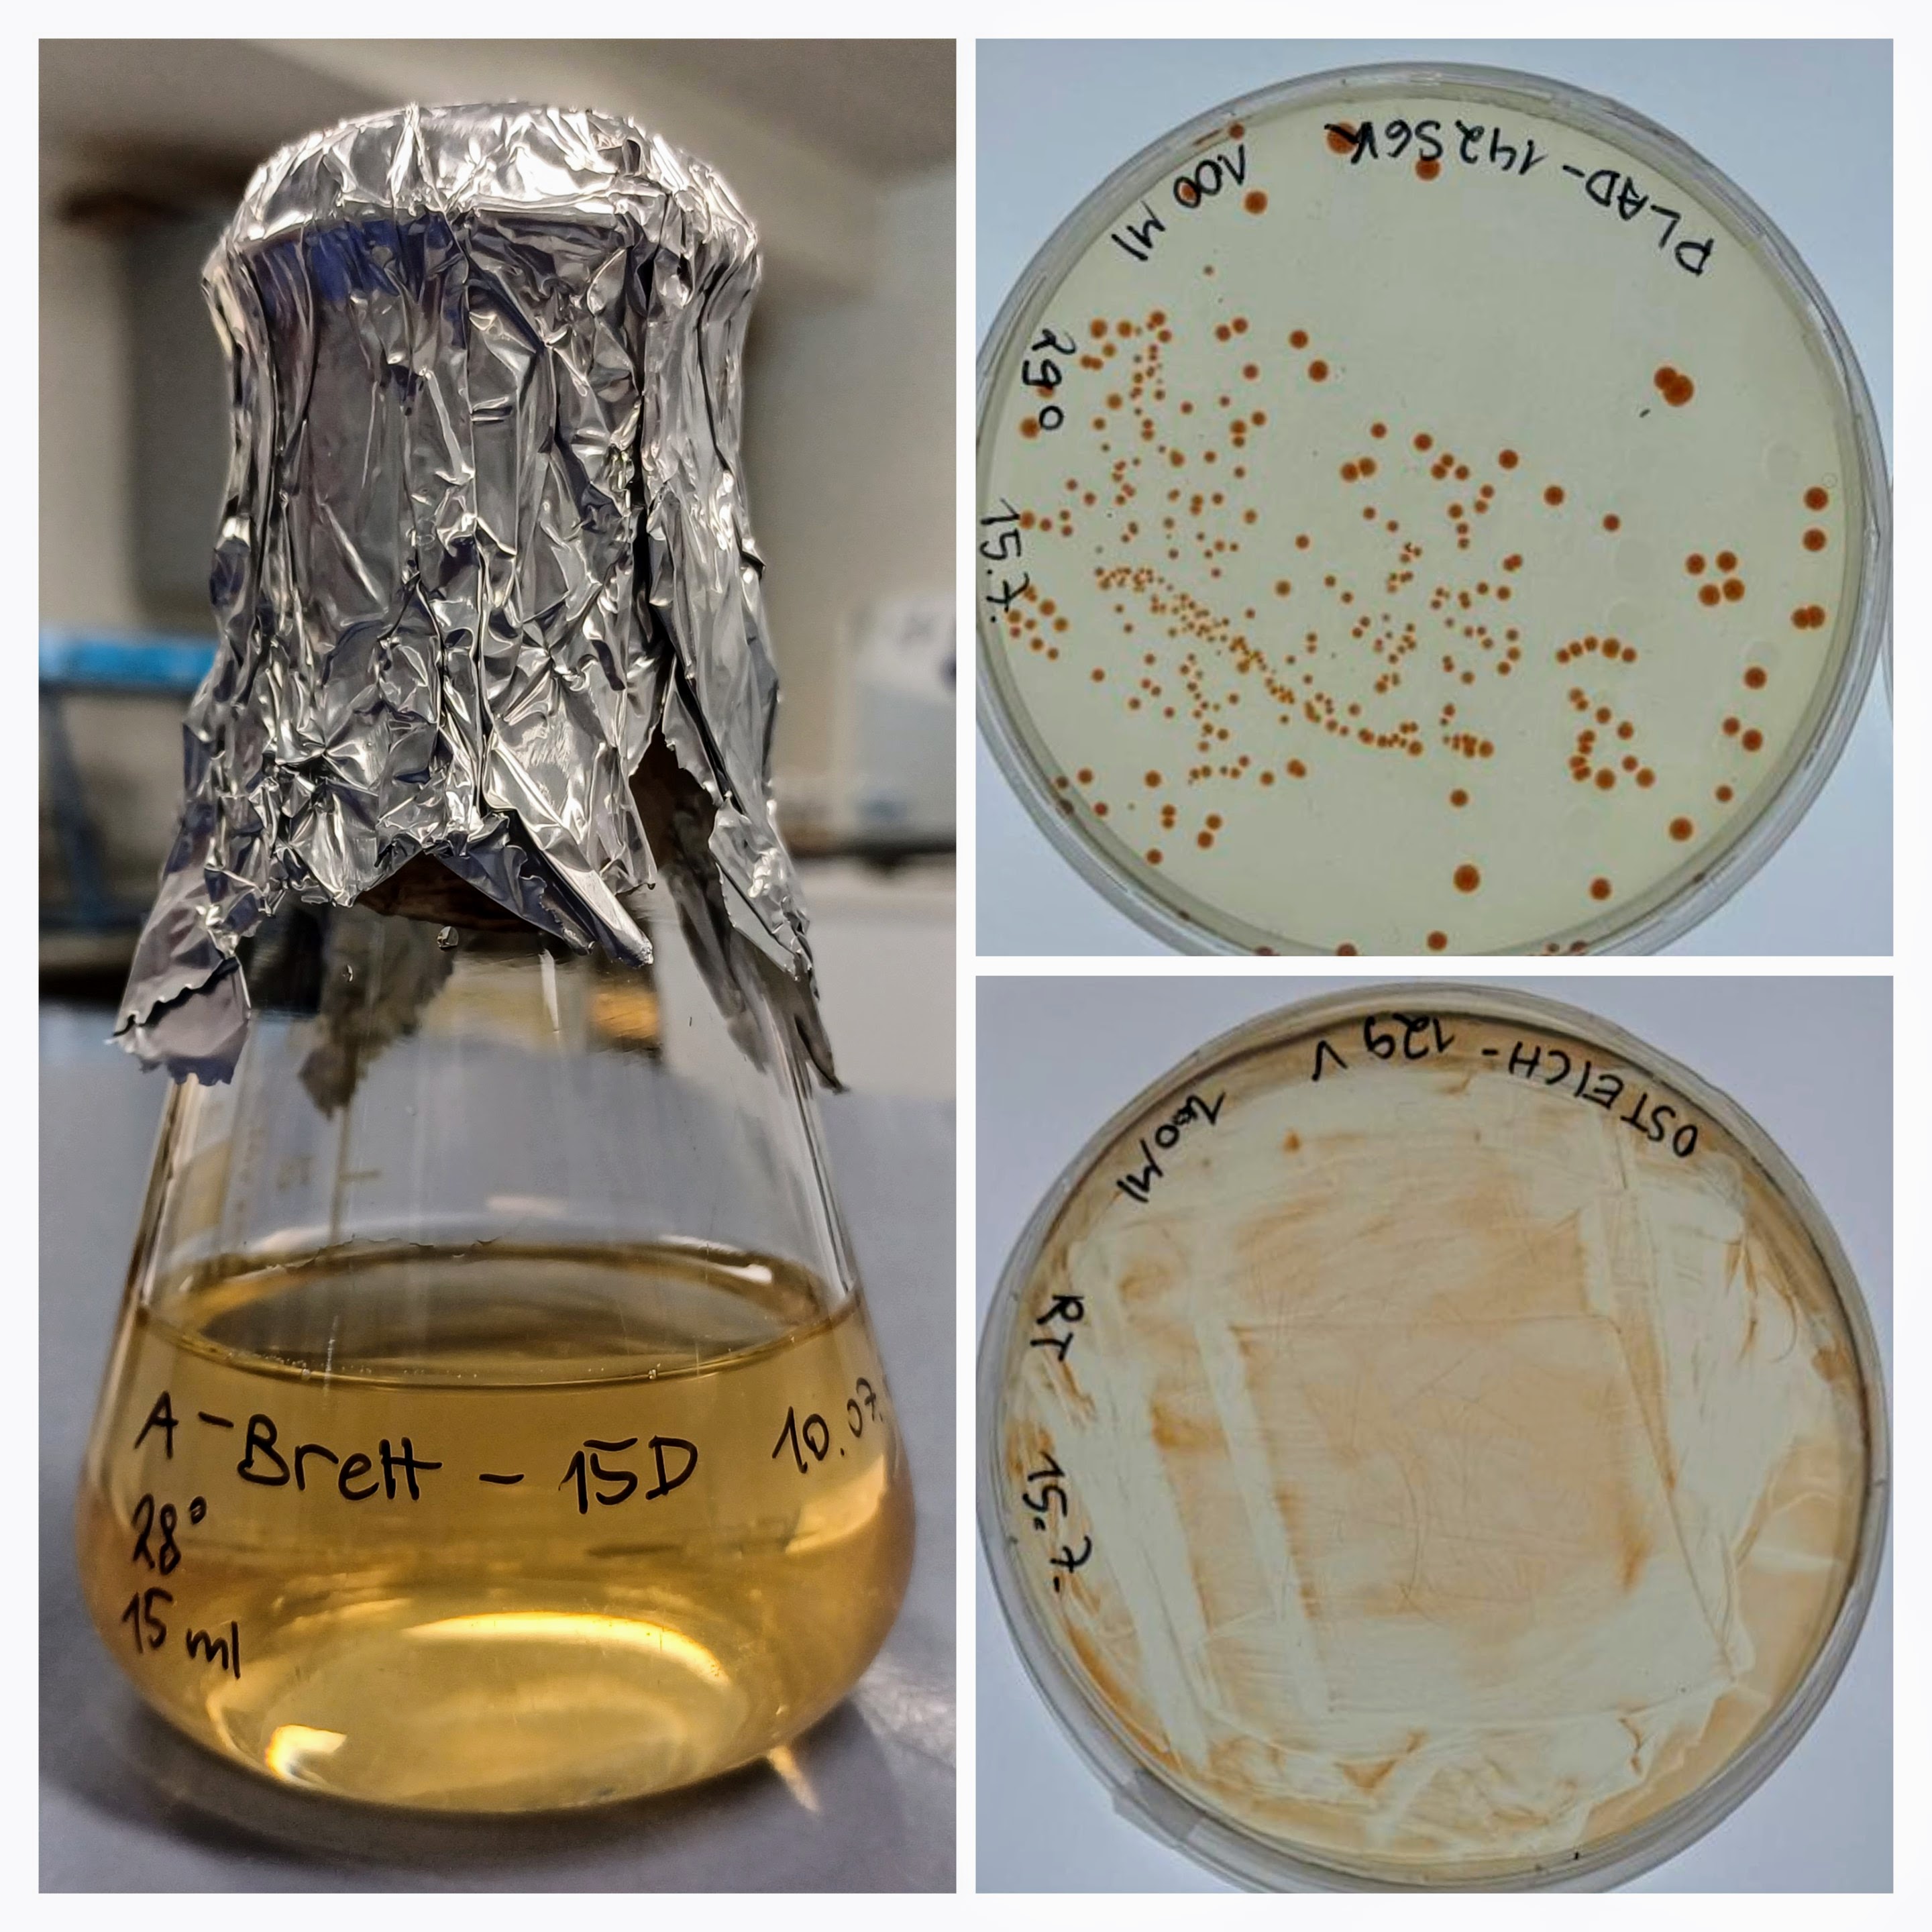

Im Sommer 2025 waren zwei Schülerinnen bei uns im Labor für ein Praktikum zu Gast. Anna hat gerade am BORG Nonntal ihre Matura mit Auszeichnung bestanden und Eva wird ihren Abschluß nächstes Jahr am BRG Schloss Wagrain machen. Die Beiden waren sehr fleißig im Gelände und Labor, hier ist ihr Bericht:
Durch ein Praktikum am Forschungsinstitut für Limnologie in Mondsee hatten wir die Möglichkeit in seriöse wissenschaftliche Arbeit hinein zu schnuppern. Wir arbeiteten mit widerspenstigen Bakterienstämmen (ABRETT2- W8) und extrem empfindlichen Messgeräten. Neben alltäglichen Aufgaben, wie den Geschirrspüler mit Kölbchen zu füllen, übernahmen wir auch Herausforderungen, wie die Benennung dreier Bakterienstämme aus Korsika (selbstverständlich ohne die nötigen Lateinkenntnisse – der Dank gilt Prof. Aharon Oren). All unsere Tätigkeiten hielten wir selbstredend in einem Protokoll fest.
Probennahme
Für die Anwerbung einiger bakteriellen Probanden ging es zunächst einmal in die Weitwörther Au und nach Bad Ischl. Die Probennahmen erfolgten am Ufer diverser Flüsse, kleinerer Seen und Teiche. Trotz der generell eher verregneten Wetterlage hatten wir das Glück, nicht allzu nass zu werden. Eigentlich gab es nur einen Umstand, der die Nerven strapazierte: die Zeit, die sich das pH-Meter ließ.
Laborarbeit
Einmal dazu überredet, mitzukommen, wollten unsere bakteriellen Mitarbeiter natürlich auch versorgt werden. Uns wurde daher die Verantwortung zuteil, den Haubenkoch zu spielen. Das Medium, dass wir herstellten, sollte eine gute Nahrungsgrundlage für die Aquirufa- Stämme bilden. Da wir aber noch nicht wussten, wie viel Würze unsere Schützlinge vertragen, stellten wir dasselbe Medium mit unterschiedlichen Salzkonzentrationen her. Auch ihre Temperaturtoleranz bestimmten wir, indem die Stämme bei Temperaturen von frostigen 4-6°C bis zu 33°C eingelagert wurden. Nachdem es zu einigen mehr oder weniger vorzeigbaren Wachstumsschüben kam (oder überhaupt nichts passierte – auch eine Erkenntnis), hatten wir eine etwas zu groß geratene Kolonie zu… versorgen. Nach dem Einsatz des Autoklavs waren die Kölbchen schon fast wieder bereit für eine neue hungrige Bakterienmeute. Zu guter Letzt durften wir die Bakterien noch unter dem Mikroskop anschauen und die kleinen, Tictac-förmigen Kerlchen vermessen. Um auch uns nicht verhungern zu lassen, gab es an manchen Tagen auch ein kleines Stück Kuchen während der Arbeitszeit. Um aus den Proben der Weitwörther Au und aus Bad Ischl die Bakterien zu isolieren, musste das Wasser zuerst gefiltert werden. Wenngleich wir diese Aufgabe nicht übernahmen, durften wir doch die Filter einsortieren und im Tiefkühlfach einlagern. Zu diesem Anlass durften wir kreativ werden und zwei Kartonboxen zu diesem Zweck modifizieren.
PCR
Viele kennen den Begriff PCR aus den Zeiten des berühmtberüchtigten Babyelefanten. Auch wir führten einen solchen Test durch, allerdings mit der Absicht, den genauen Platz unserer Schützlinge im Stammbaum zu finden. Dafür musste erst einmal ein Mastermix hergestellt werden, eine Mischung aus Enzymen und Basenbausteinen, um die DNA zu vervielfältigen. In der Maschine, die den nächsten Schritt übernahm, wurden durch Temperaturregulation Duplikate der Original DNA gebaut. Danach wurden die DNA-Stücke in ein Gel getropft und durch Anlegen einer Spannung der Größe nach sortiert. Das entstandene Streifenmuster konnte mit Hilfe von UV-Licht ausgewertet werden.
Rhodopsine
Einigen der Stämme, mit denen wir arbeiteten, weisen das Gen für Rhodopsine auf, ein Protein, das auch in unserer Netzhaut vorkommt. Bakterien verwenden es für einen Prozess, der dem der Photosynthese ähnelt. Um heraus zu finden, ob unsere Bakterien diese Fähigkeit ebenfalls besitzen, führten wir zwei Versuche mit ihnen durch. Dafür wurden sie zunächst auf Diät gesetzt. Nach einigen Tagen ohne Futter und ohne Licht wurden die Stämme in kurzen Intervallen mit starkem Licht bestrahlt. Die Messungen des mäßig funktionierenden PH-Meters sollten dabei Aufschluss über den Gebrauch der Rhodopsine geben. In einem zweiten Experiment zu diesem Thema, welches wir (mit Hilfe) selbst in unserem provisorischen „Büro“ erarbeiteten, fingen wir an einen Vergleich herzustellen zwischen einer Kultur in normalen Lichtverhältnissen und einer, die Starklicht ausgesetzt war. Dieser Unterschied sollte sich durch Auftropfen auf einer Agarplatte zeigen. Da dieses Experiment noch eine Zeit laufen wird, bleiben die Ergebnisse spannend.